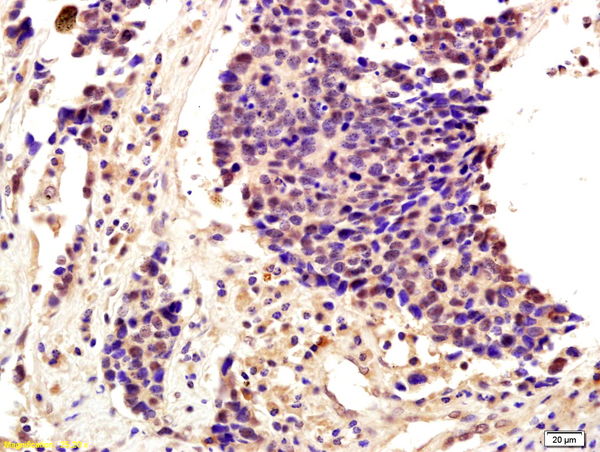

Formalin-fixed and paraffin embedded human colon cancer labeled with Anti-SNAI2/SLUG Polyclonal Antibody, Unconjugated (bs-1382R) followed by conjugation to the secondary antibody and DAB staining
SNAI2 Polyclonal Antibody
BS-1382R
ApplicationsImmunoFluorescence, Western Blot, ELISA, ImmunoCytoChemistry, ImmunoHistoChemistry, ImmunoHistoChemistry Frozen, ImmunoHistoChemistry Paraffin
Product group Antibodies
ReactivityBovine, Canine, Chicken, Human, Mouse, Porcine, Rabbit, Rat
TargetSNAI2
Overview
- SupplierBioss
- Product NameSNAI2 Polyclonal Antibody
- Delivery Days Customer16
- ApplicationsImmunoFluorescence, Western Blot, ELISA, ImmunoCytoChemistry, ImmunoHistoChemistry, ImmunoHistoChemistry Frozen, ImmunoHistoChemistry Paraffin
- Applications SupplierWB(1:300-5000), ELISA(1:500-1000), IHC-P(1:200-400), IHC-F(1:100-500), IF(IHC-P)(1:50-200), IF(IHC-F)(1:50-200), IF(ICC)(1:50-200)
- CertificationResearch Use Only
- ClonalityPolyclonal
- Concentration1 ug/ul
- ConjugateUnconjugated
- Gene ID6591
- Target nameSNAI2
- Target descriptionsnail family transcriptional repressor 2
- Target synonymsSLUG, SLUGH, SLUGH1, SNAIL2, WS2D, zinc finger protein SNAI2, neural crest transcription factor SLUG, protein snail homolog 2, slug (chicken homolog), zinc finger protein, snail family zinc finger 2, snail homolog 2
- HostRabbit
- IsotypeIgG
- Protein IDO43623
- Protein NameZinc finger protein SNAI2
- ReactivityBovine, Canine, Chicken, Human, Mouse, Porcine, Rabbit, Rat
- Storage Instruction-20°C
- UNSPSC41116161
References
- Nicotinamide inhibits corneal endothelial mesenchymal transition and accelerates wound healing. Li Z et al., 2019 Jul, Exp Eye ResRead this paper
- The zinc-finger transcriptional factor Slug transcriptionally downregulates ERalpha by recruiting lysine-specific demethylase 1 in human breast cancer. Bai JW et al., 2017 May 8, OncogenesisRead this paper